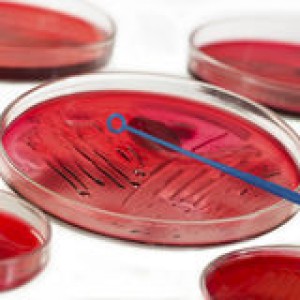

News
Campden BRI announces microbiology conference
6 Aug 2015Food poisoning and spoilage are never far from the spotlight, notes Campden BRI. The company’s annual conference on microbiology ‘hot topics’ will be held on 8-9 October and will look at various areas of concern and keep delegates up-to-date with the latest information and thinking. There will be opportunities for discussion on a range of […]
Food poisoning and spoilage are never far from the spotlight, notes Campden BRI. The company’s annual conference on microbiology ‘hot topics’ will be held on 8-9 October and will look at various areas of concern and keep delegates up-to-date with the latest information and thinking. There will be opportunities for discussion on a range of microbiological issues with news and updates on food production related topics.
Food poisoning and spoilage are never far from the spotlight, notes Campden BRI. The company’s annual conference on microbiology ‘hot topics’ will be held on 8-9 October and will look at various areas of concern and keep delegates up-to-date with the latest information and thinking. There will be opportunities for discussion on a range of microbiological issues with news and updates on food production related topics.
“This year, the conference will include presentations and discussions on Campylobacter, STEC, clostridia and viruses,” said Event Director Fiona Cawkel. “We will also be looking at predictive microbiology, food irradiation, the hygienic design of food manufacturing lines, and soft drinks microbiology – all in all, a fascinating and varied programme.”
